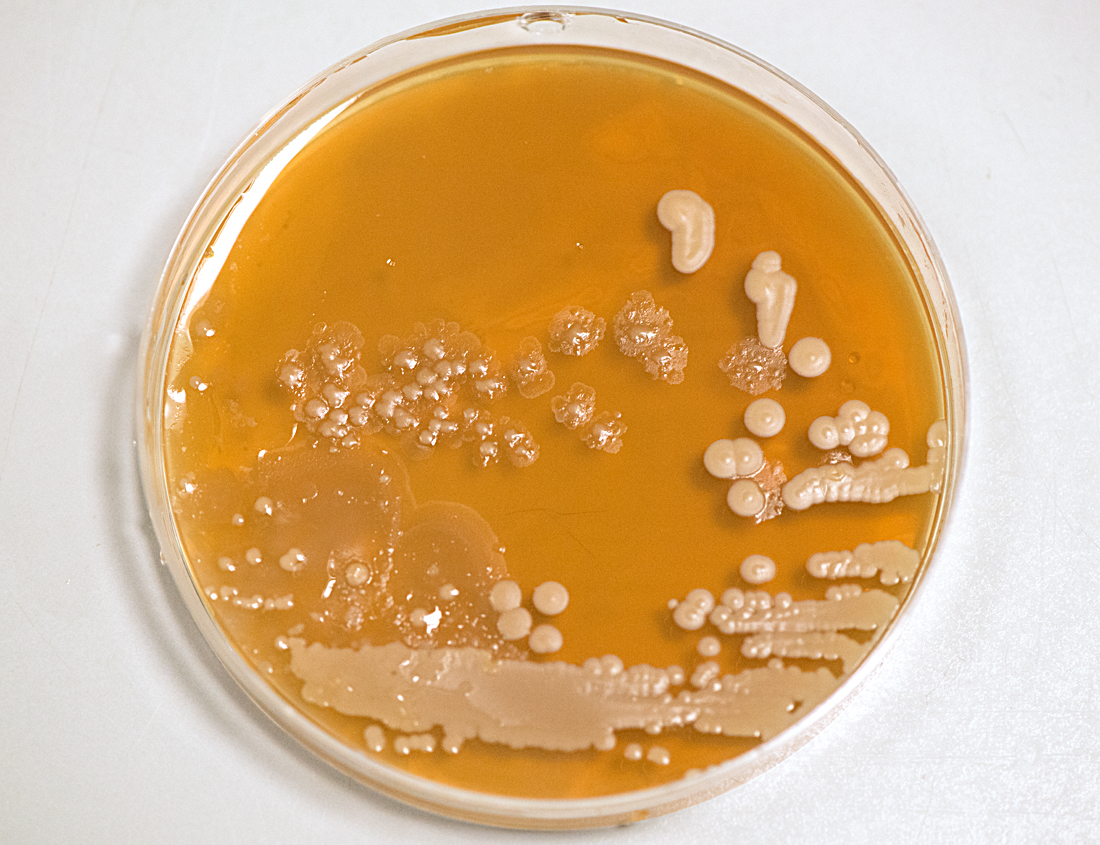
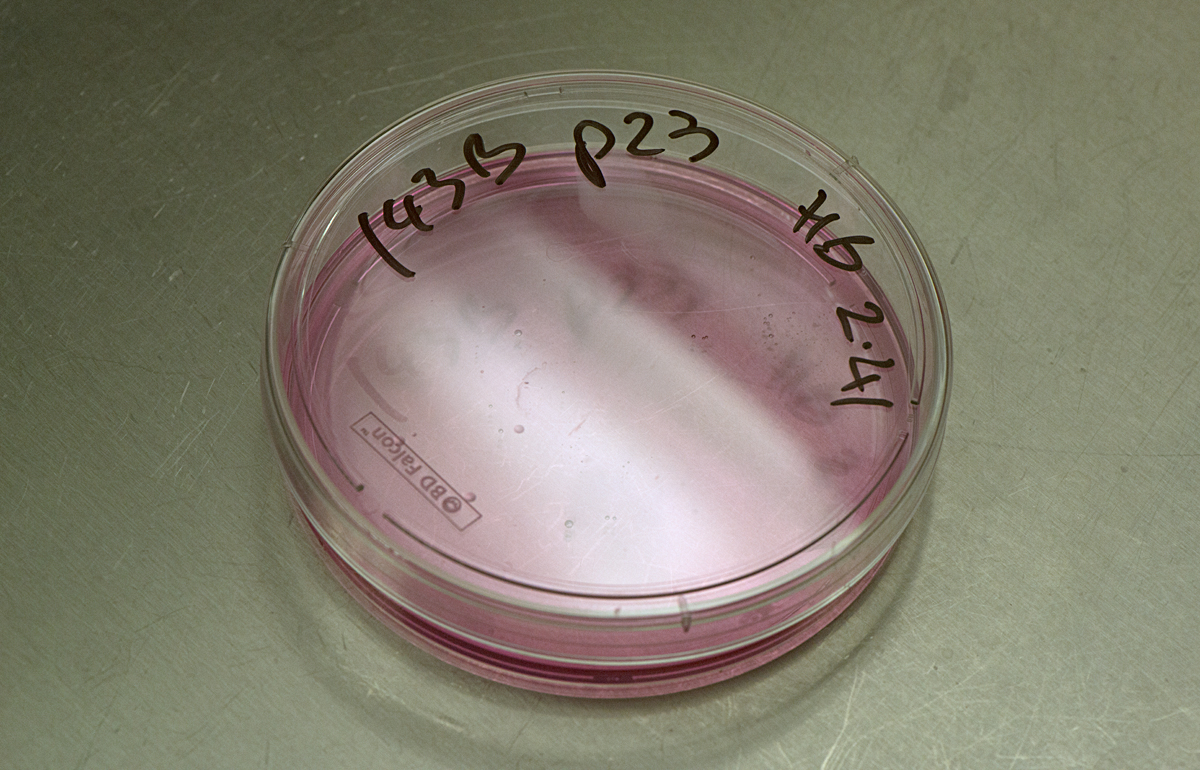
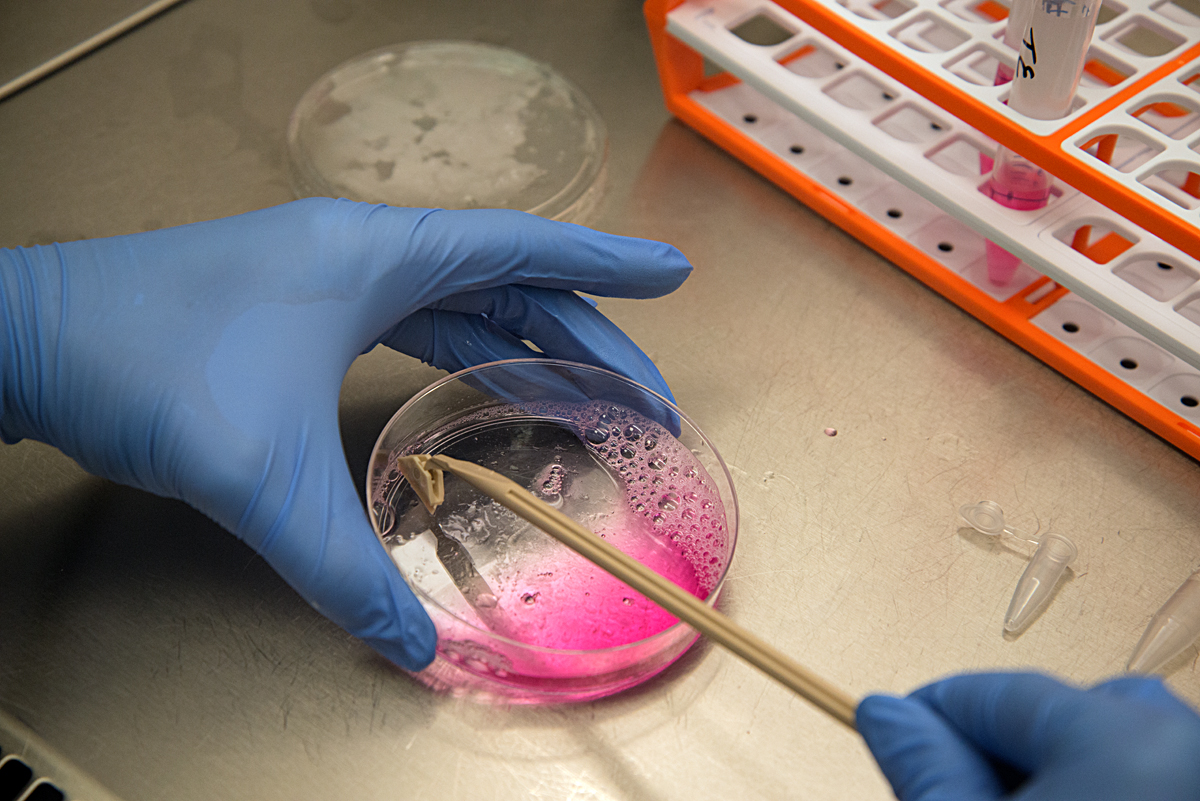

about the lab visits
The Fox Got You is an art and science project celebrating common plants at the origin of medicinal drugs (for an overview, go to the home page). For the project artist Françoise Sergy visited three biochemistry laboratories, at the MRC Mitochondrial Biology Unit in Cambridge (MBU), the William Harvey Research Institute in London (WHRI) and the Centre for Mechanochemical Cell Biology at the University of Warwick (CMCB). She wanted to photograph some of the work taking place and see how biochemistry research is done on a day to day basis. She was aware that she wouldn't understand in a meaningful way what was happening but her camera gave her access and she was welcomed.
The scientists told her about the biological material used in their research and about the issues surrounding where this material comes from. This aspect of their work is governed by strong ethical codes and is strictly regulated. For example, human cancer cells have been approved for research use since the 1960’s, originally from donors and kept alive in incubators. At the MBU, where mitochondria are studied, one source of the organelles is fresh yeast, which is grown in a fermentor under the watchful eye of a scientist. Another source used in some labs is the waste left from meat production for food consumption. At the CMCB, where microtubules are studied, the scientists go to abattoirs to collect unwanted pigs brains, then extract the cells directly in the lab. To an outside eye this practice could appear to be somewhat unsafe. However, the process is regulated and is a reliable way for these scientists to access cells which are then studied through live cell imaging. At the WHRI, the artist was reminded of the extremely delicate nature of the structures studied. There, research on cardiovascular disorders focuses on human blood cells. These cells do not survive freezing and are damaged after a short period of cold storage. So, when the research does not require random blood samples to be obtained, a system of blood donation has been set up amongst the scientists themselves.
The science lab world was completely unknown to the artist before her visits. Although she found it fascinating, she felt completely out of her depth, with every type of equipment and even the most basic procedure meaning nothing. The lab benches were filled with equipment, machines, tubes, pipettes, jars, notebooks and other scientific paraphernalia. The activity was very focused and methodical. Scientists do the core of their biochemistry work at open benches but there is equipment for specialised work: Laminar flow cabinets are used when they need to work in a very clean environment, to prevent the contamination of the material they are studying. Air into the cabinet is filtered and blown out in a laminar flow, protecting both the material and the scientist. A nitrogen glove box is a more extreme type of cabinet, used when oxygen must not be allowed to interfere with the substances studied. The box is filled with nitrogen instead of filtered air and the scientists reach inside through thick black gloves attached directly to the box.
Assay work involves a lot of very precise measuring and pipetting liquid compounds and cellular material from and into tubes and plates, in strict order and according to a 'recipe'. Some of the assay results are determined visually, for example when a sample’s protein or iron concentration is assessed by its colour: In each cell of a 96 well plate, a compound is diluted to a different amount, then mixed with a reagent which changes colour according to the amount of protein or iron present. The colour of these cells is then compared to that of samples containing a known amount of protein or iron, which are called standards. This work is one of the many steps required for the scientists to elucidate how proteins behave within cells.
Some instruments use light to detect the concentration levels of molecules. At the MBU an absorbance detection plate reader uses light of a specific wavelength to illuminate each sample on a plate. On the other side of the sample, a light detector measures how much light passes through. This figure correlates with the sample’s molecular concentration. At the WHRI, an aggregometer measures the degree of blood platelets’ aggregation over time, in response to an added aggregating agent, again by determining the amount of light passing through the sample: As the platelets aggregate, more light can pass through the blood plasma. Chromatography is used to separate, purify or analyse complex mixtures. The process is akin to a substance going through a maze: molecules with more affinity to the maze’s particles are trapped and delayed whilst molecules with less affinity go through the maze quicker. At the MBU, this is used to fractionate mitochondrial proteins.
Microscopes are an essential part of biochemistry research, including for viewing the activities of living cellular structures. Each lab has to develop specific methods of preparing the glass slides, sometimes using every day tools to achieve this: At the CMCB a thin well is made on the slide with the help of sellotape and candle wax. Optical microscopes placed on a lab bench are used to look at cells in a petri dish, to study their behaviour or to count them. More specialised microscopes are huge and take up lots of space in darkened rooms, where scientists spend hours viewing the specimens and interpreting the digital computer images. A fluorescence microscope uses fluorescence to generate an image: The microscope emits light of a specific wavelength. A fluorescent stain added to the specimen absorbs this wavelength and re-emits light at a lower wavelength: for example blue light is re-emitted as green light and green light as red light. By staining each structure within the cell with a specific stain and by using different light wavelengths, a digital picture of the specimen is built up which shows the structures in different colours, making them easier to visualise and study. A confocal microscope uses lasers to focus on a specific plane within the specimen’s thickness. By adding each focal plane view into one image, a 3D digital picture is built up showing the specimen’s various layers. At the CMCB, a widefield fluorescence microscope is used for live cell imaging, usually in long-term timelapse experiments of 12 hours or so, to see how cells move and divide.
MRC Mitochondrial Biology Unit (MBU)
The MRC Mitochondrial Biology Unit is a world-leading institution based at the Bio-Medical Campus in Cambridge, Britain. It was originally founded in 1927 under the name of the MRC Dunn Human Nutrition Unit. The Unit has three major scientific aims: firstly, to understand the fundamental processes taking place in mitochondria, the cellular organelles responsible for generating our body’s energy; secondly, to understand how these processes are involved in human diseases and thirdly, to use this knowledge for the development of new therapies. Professor Sir John Walker was Director of the Unit between 1998 and 2013 and has continued his research there since. Sir John won the Nobel Prize for the elucidation of the mechanism of action of the enzyme which makes ATP, our body’s basic unit of energy. You can listen to his interview below. For a link to the Unit's website, please go to the Links page.
Dr Hannah Bridges is an Investigator Scientist whose work focuses on the study of an enzyme called complex I. She is a member of the research group lead by Dr Judy Hirst. Here she describes one of theirs studies, the Mitochondrial complex I and Metformin Study, published in 2014:
"Mammalian cells contain cellular compartments (organelles) called mitochondria. Within mitochondria a crucial group of enzymes, called the respiratory chain, are responsible for extracting energy from foods: They use the oxygen we breathe to efficiently 'burn' dietary lipids (fats) and carbohydrates (sugars). Important steps in this process generate a compound called NADH. As part of the respiratory chain, an enzyme called 'complex I' uses NADH to initiate a set of reactions that charge up the mitochondrial membrane like a biological battery. This 'battery' then provides a source of power for the generation of ATP (adenosine triphosphate), the 'energy currency' that is used to drive all the processes of life in our cells. Complex I is essential for balancing energy supply-and-demand in the cell. Problems with complex I, such as dysfunctions caused genetically or by environmental factors, are involved in a wide variety of diseases and conditions, ranging from Parkinson’s Disease to the sudden onset blindness known as Leber’s Hereditary Optic Neuropathy. Loss of complex I function (its inhibition) is central to all these diseases.
However, it has been proposed by researchers that the clinical benefits of Metformin, the widely used anti-diabetic drug, also result from the inhibition of complex I. In this instance, the loss of complex I function may actually be helping to control diabetes: Metformin’s action as a drug may be causing a loss of cellular energy, which in turn may initiate cellular responses that lower blood glucose, the key aim in diabetes treatment. This presents us with a fascinating biomedical conundrum. Striking the correct energy supply-and-demand balance is a challenge: Too much complex I inhibition will result in a serious condition called lactic acidosis. While Metformin is uniquely suited to maintaining this balance, other potential anti-diabetic drugs similar to Metformin, such as Phenformin, have been withdrawn from use because the risk of lactic acidosis is too high with them.
The aim of our study was to assess how complex I interacts with Metformin and other related drug compounds from the 'biguanide family', including the former anti-diabetic drug Phenformin and the anti-malarial drug Proguanil. We showed that all these biguanide drugs inhibit complex I. However, we also showed that their effects on the mitochondria and in the cell are governed by the amount of the drug that is able to reach its complex I target. Indeed, whilst our purified complex I enzyme required extremely high concentrations of Metformin to be inhibited by it, we also found that the drug accumulated inside the mitochondria. Metformin is positively charged and a charge difference across the mitochondrial boundary membrane caused it to accumulate inside the mitochondria. Perhaps this charge-dependent accumulation helps to make Metformin such a safe drug for the treatment of diabetes: Too much accumulation inhibits complex I so the charge difference decreases, forming a positive feedback loop that prevents an energy crisis developing along the respiratory chain. Furthermore, the anti-malarial drug Proguanil is a much more potent inhibitor of complex I than Metformin, when the enzyme is in its purified form – so why is Proguanil so safe? We discovered that Proguanil is unable to enter mitochondria, presumably because the protein carriers that transport molecules through the mitochondrial membrane do not recognise it. Proguanil circulates safely in the bloodstream, where it acts to kill the malaria parasite, without ever entering the mitochondria and affecting complex I.
Clearly, it is important to combine both basic science research and clinical studies, if we are to obtain a full molecular and physiological picture of how medicines really work, some of which have been used for centuries to combat common diseases."
The Mitochondrial complex I and Metformin Study was published as: Biochem J. 2014 Sep 15;462(3):475-87. doi: 10.1042/BJ20140620. Effects of metformin and other biguanides on oxidative phosphorylation in mitochondria. Bridges HR, Jones AJ, Pollak MN, Hirst J
Centre for Mechanochemical Cell Biology (CMCB)
The Centre for Mechanochemical Cell Biology is based at the Warwick Medical School, the University of Warwick in Coventry, Britain. Its research focuses on cell biology as a biomedical subject area at the interface of physics, chemistry and biology. Its mission is to discover molecular mechanisms and principles of active self-organisation in living systems, and to apply the new knowledge, via collaboration, to improve human health and wellbeing. For a link to the Centre's website, please go to the Links page. Dr Anne Straube is Associate Professor in Mechanochemical Cell Biology at the CMCB. Below, she explains how the cancer drugs Paclitaxel and Docetaxel work:
"Within cells, microtubules are filamentous structures formed of a protein called tubulin. These hollow fibres act as a skeletal system inside the cell. They are involved in giving the cell its shape, in transporting organelles and molecules within the cell and they play a major role in the separation of chromosomes during cell division. Unlike our skeleton, the microtubule cellular skeleton is highly dynamic, continuously assembling and disassembling.
Cancer cells divide rapidly once they become able to evade the body’s control mechanisms that normally ensure a constant number of cells is maintained. The chemotherapy drugs Paclitaxel / Docetaxel (brand names Taxol / Taxotere) interfere with cell division - any cell division. This is why the drugs affect other cells in the body, not just the cancer cells: Particularly affected are cells which naturally divide rapidly, such as those in hair follicles and the immune system. During treatment, by preventing cell division, the drugs cause the cancer cells to die and the tumour to shrink. Chemotherapy is one of the tools used to destroy cancer, often in combination with surgery and radiotherapy. The treatment aims firstly to remove the localised cancer cells through surgery; secondly, through chemotherapy, to prevent the growth of the cancer cells not removed by surgery; thirdly, to destroy the cells which are still alive locally after that, through radiation.
Microtubules have two very important roles in cell division: They form suitable arrays, which change as needed and they generate pushing and pulling forces. During cell division, a spindle is formed made out of microtubules, which pushes and pulls the chromosomes into proper alignment and segregation, in order to achieve their separation. In the presence of Paclitaxel / Docetaxel, microtubules can no longer disassemble and the spindle development is disrupted. Cells get stuck in the middle of the division process and many of them die after a while. As cancer cells divide more often than non-cancer cells, the drugs kill cancer cells preferentially. The stabilisation of microtubules also inhibits their function in cell migration, so we think that the drugs may also help limit the spread of the cancer, by reducing the movement of cancer cells to other parts of the body. The drugs bind to tubulin in a small pocket on the inside of the microtubule. By doing so, they stabilise the microtubule and prevent it from disassembling. We think they do this by moving a loop in the tubulin, causing a stronger bond to form between neighbouring tubulin subunits. Once the subunits in the microtubule wall have bonded more strongly to each other, it becomes very difficult for the microtubule to disassemble. Colchicine, the drug used in gout treatment, also affects microtubules and cell division. Research is taking place on its potential use as a cancer drug but its high toxicity has so far prevented a breakthrough. Colchicine works in a different way to Paclitaxel / Docetaxel: It prevents microtubule assembly. In their non active phase, the microtubules subunits have a curved shape, which must straighten for them to be able to assemble. When colchicine is bound to these subunits, they can no longer straighten and microtubule assembly is disrupted.
Our work at the lab focuses on the role of microtubules in cell migration from one part of the body to another. We investigate how the dynamic microtubules function during cell migration, how they regulate the machinery that drives this migration. We study the process at various levels: by spending time observing the migration of cells; by using imaging tools to study the dynamics of various cell components; by developing lab techniques to perturb the function of individual proteins and analysing the changes that occur with the help of computer tools; by looking at tubulin and purified proteins in vitro and analysing how microtubule dynamics are regulated.
Paclitaxel / Docetaxel also affect another function of microtubules: the transport of molecules and other structures within cells. This is particularly damaging to nerve cells. Neurons are very long cells, which rely extensively on microtubular transport to move structures from one area to another. They have cellular extensions - the neurites, that can be as long as one meter in the human body. For example, the transport of vesicles along a neurite takes up to three days when using a 'motor' that walks along microtubules but would take seventy years through diffusion alone. Patients treated with Paclitaxel / Docetaxel are therefore at risk of developing neuropathies, a side effect they could suffer from for years after chemotherapy. Because of these long-term side effects, we need to develop drugs, which only inhibit microtubule processes in cell division and migration and leave the neuronal transport intact. For this, we must understand the various microtubule processes of each type of cells and develop highly specific inhibitors."
William Harvey Research Institute (WHRI)
The William Harvey Research Institute, in London, Britain, was founded by the Nobel Laureate Sir John Vane in 1985. Sir John won the Nobel Prize for discovering how Aspirin works and identifying Prostacyclin, which is now used to treat pulmonary hypertension. The Institute was first established at St. Bartholomew's Hospital in London. In 1996, it became part of Barts and the Royal London School of Medicine and Dentistry (Queen Mary University). The focus of its research is the study of cardiovascular, inflammation and endocrine diseases, and the discovery of innovative therapies. For a link to the Institute's website, please go to the Links page. Roderick Flower is Professor of biochemical pharmacology at the Institute. He was one of the original team members working with John Vane. You can listen to his interview below.
Tim Warner is professor of vascular inflammation at the Institute. Here he describes his department’s research:
"We are pharmacologists with a principle interest in the interplay between the blood, blood vessels and therapeutic drugs that protect against heart attacks and strokes. Platelets are small cells (actually not whole cells as they have no nucleus) that circulate around in the blood and can stick together rapidly to stop bleeding. The average human has over a trillion platelets in their body. Our research investigates how systems in the body control the activity of the platelets, and how these systems interact with drugs used to prevent heart attacks and strokes.
The insides of all blood vessels, arteries and veins, including the smallest ones, the capillaries, are lined with cells which are called endothelial cells. While these cells have been of great interest to biomedical researchers for the last 30 years or so, their name doesn’t usually mean much to the general public. They are present in very large numbers throughout our bodies - if all the endothelial cells in an average human were laid end to end they could stretch more than four times around the earth. This means that collectively our endothelial cells could be seen as one of our largest body organs. These cells have many functions, including fluid filtration in the kidneys; blood vessel toning; haemostasis, which is a process that causes bleeding to stop; the recruitment of neutrophils, which are a type of white blood cells; and the movement of hormones.
One area of our research is the interaction between platelets and endothelial cells. If blood vessels get cut or broken, the platelets detect this change, they become activated and stick to the broken surfaces of the vessel. This activity causes the formation of a blood thrombus, or clot, to block up the hole and stop blood loss. This is called haemostasis. However, it is important that platelets do not form clots when the blood vessels are not damaged, as these clots can lead to blockage in the veins and arteries, which can then cause heart attacks and strokes. This is where the endothelial cells come in: They release local hormones, in particular nitric oxide and prostaglandin I2, that maintain the platelets in their inactivated state, so stopping them from blocking up healthy blood vessels.
People who are at risk of heart attacks or strokes take drugs to "thin the blood", in order to decrease the risk of clot formation. By "thinning the blood" we mean different things, depending on the treatment required and the drugs used. One group of drugs are the anti-platelets drugs, which reduce the activation of platelets. The most well known amongst these is Aspirin. For people most at risk however, the drugs known as P2Y12blockers are more effective. Warfarin is another type of anticoagulant which works in a different way.
Our research at the Institute studies how these anti-platelets drugs interact with the platelets and the hormones produced by endothelial cells, to regulate the formation of blood thrombi. One way we follow this is to use advanced microscopy techniques and the labelling of individual platelets to see how platelets treated with drugs interact with untreated platelets. This helps us understand the mechanisms by which our trillion platelets interact and are affected by clinical therapies."